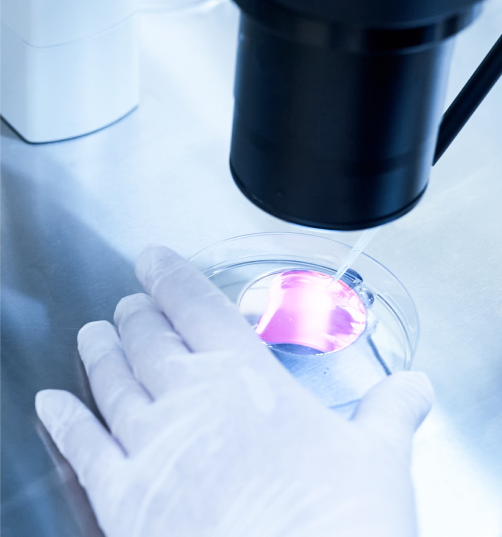

AIM: Fertility Patients
Receptivity Test
Better insights. Better timing. A better chance at the future you dream of.

Empowering Your
Journey to Parenthood
When you’re growing your family, having the right information at the right time can make all the difference.AIM gives your fertility team a smarter, faster way to assess endometrial receptivity, helping ensure every step of your journey is as informed and personalized as possible.
Built on the proven science behind Matris™, AIM enhances endometrial assessment with the power of Artificial Intelligence (AI) and Machine Learning (ML). By analyzing ultrasound images quickly and precisely, AIM helps your care team determine the optimal timing for embryo transfer, without additional medications, procedures, or changes to your fertility treatment plan.
How AIM Supports You
AIM provides fertility specialists and technologists with important information about the status of the endometrium, the lining of the uterus. Fertility specialists can then use this information to help determine the best time for an embryo to be implanted into the uterus. The process is simple:
Non-invasive
Uses ultrasounds, which are already part of your care.
Fast results
AI-driven analysis for quicker insights.
Built on trusted science
Evolved from the Matris™ test with next-generation technology.
Personalized approach
Helps your doctor fine-tune timing for your best chance at success.